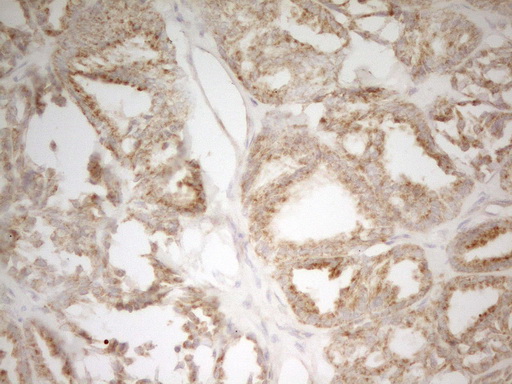

MRPL15 Mouse Monoclonal Antibody [Clone ID: OTI7A3]
CAT#: TA807342
MRPL15 mouse monoclonal antibody, clone OTI7A3 (formerly 7A3)
Size: 30 ul
Formulation: Carrier Free
USD 436.00
Specifications
| Product Data | |
| Clone Name | OTI7A3 |
| Applications | IHC, WB |
| Recommended Dilution | WB 1:2000, IHC 1:150 |
| Reactivities | Human, Mouse |
| Host | Mouse |
| Isotype | IgG2b |
| Clonality | Monoclonal |
| Immunogen | Human recombinant protein fragment corresponding to amino acids 28-296 of human MRPL15(NP_054894) produced in E.coli. |
| Formulation | PBS (pH 7.3) containing 1% BSA, 50% glycerol and 0.02% sodium azide. |
| Concentration | 1 mg/ml |
| Purification | Purified from mouse ascites fluids or tissue culture supernatant by affinity chromatography (protein A/G) |
| Conjugation | Unconjugated |
| Storage | Store at -20°C as received. |
| Stability | Stable for 12 months from date of receipt. |
| Predicted Protein Size | 33.2 kDa |
| Gene Name | mitochondrial ribosomal protein L15 |
| Database Link | |
| Background | Mammalian mitochondrial ribosomal proteins are encoded by nuclear genes and help in protein synthesis within the mitochondrion. Mitochondrial ribosomes (mitoribosomes) consist of a small 28S subunit and a large 39S subunit. They have an estimated 75% protein to rRNA composition compared to prokaryotic ribosomes, where this ratio is reversed. Another difference between mammalian mitoribosomes and prokaryotic ribosomes is that the latter contain a 5S rRNA. Among different species, the proteins comprising the mitoribosome differ greatly in sequence, and sometimes in biochemical properties, which prevents easy recognition by sequence homology. This gene encodes a 39S subunit protein that belongs to the EcoL15 ribosomal protein family. A pseudogene corresponding to this gene is found on chromosome 15q. [provided by RefSeq, Jul |
| Synonyms | HSPC145; L15mt; MRP-L7; MRP-L15; RPML7 |
| Reference Data | |
Documents
| Product Manuals |
| FAQs |
| SDS |
Resources
| Antibody Resources |
{0} Product Review(s)
Be the first one to submit a review






























































































































































































































































 Germany
Germany
 Japan
Japan
 United Kingdom
United Kingdom
 China
China